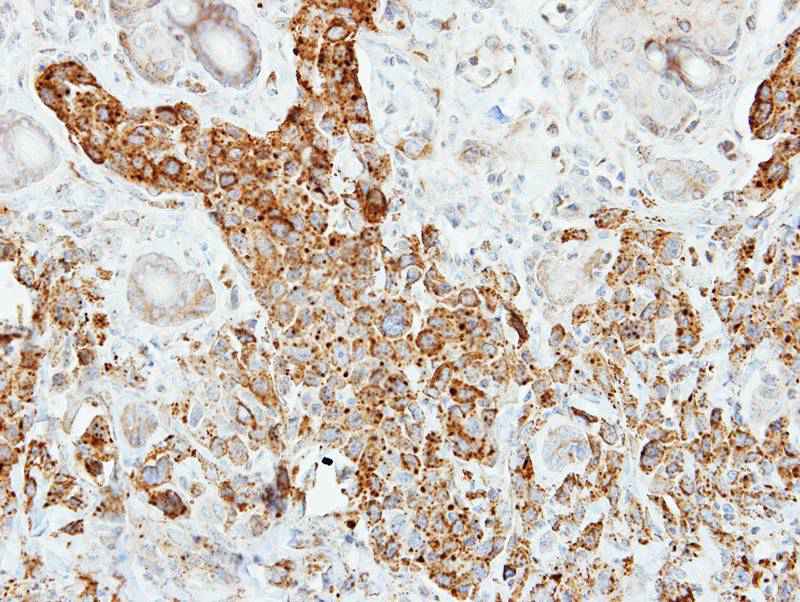
Pancreatic Lipase antibody

相关产品推荐更多 >
万千商家帮你免费找货
0 人在求购买到急需产品
- 详细信息
- 技术资料
- 免疫原:
Recombinant protein fragment contain a sequence corresponding to a region within amino acids 21 and 270 of Pancreatic Lipase
- 形态:
liquid
- 保存条件:
Store at -20˚C
- 克隆性:
Polyclonal
- 适应物种:
Human
- 保质期:
12 months
- 抗原来源:
Rabbit
- 供应商:
南京赛戈巍生物科技有限公司
- 宿主:
Rabbit
- 应用范围:
WB IHC IF
- 抗体英文名:
Pancreatic Lipase antibody
- 规格:
50ul/100ul
配方:Supplied in 0.1M Tris-buffered saline with 10% Glycerol (pH7.0). 0.01% Thimerosal was added as a preservative.
应用详情:Predicted MW: 51kd
Western blotting: 1:500-1:3000
Immunohistochemistry: 1:50-1:500
Immunofluorescence: 1:100-1:200
图片:
应用详情:Predicted MW: 51kd
Western blotting: 1:500-1:3000
Immunohistochemistry: 1:50-1:500
Immunofluorescence: 1:100-1:200
图片:

Sample (30 ug of whole cell lysate)
A: 293T
10% SDS PAGE
Primary antibody diluted at 1: 1000
,
Immunohistochemical analysis of paraffin-embedded SCM-1 xenograft, using Pancreatic Lipase antibody at 1: 500 dilution.
,

Immunofluorescence analysis of paraformaldehyde-fixed A549, using Pancreatic Lipase antibody at 1: 200 dilution.
风险提示:丁香通仅作为第三方平台,为商家信息发布提供平台空间。用户咨询产品时请注意保护个人信息及财产安全,合理判断,谨慎选购商品,商家和用户对交易行为负责。对于医疗器械类产品,请先查证核实企业经营资质和医疗器械产品注册证情况。
技术资料暂无技术资料 索取技术资料
Pancreatic Lipase antibody
询价





![LEFTY1 + LEFTY2 Conjugated Antibody[C56722]](https://img1.dxycdn.com/p/s14/2025/0922/632/2321321568067599691.jpg!wh200)
![BRINP1 Conjugated Antibody[C36400]](https://img1.dxycdn.com/p/s14/2025/0923/278/4431488150116040791.jpg!wh200)
![ABHD12 Antibody[34367]](https://img1.dxycdn.com/p/s14/2025/0922/359/6146153295428599691.jpg!wh200)
